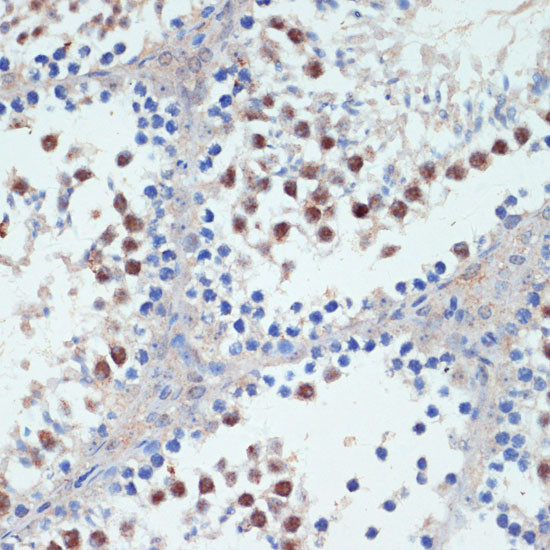
RXRG Antibody in Immunohistochemistry (Paraffin) (IHC (P))

Search
Invitrogen
RXRG Polyclonal Antibody
{{$productOrderCtrl.translations['antibody.pdp.commerceCard.promotion.promotions']}}
{{$productOrderCtrl.translations['antibody.pdp.commerceCard.promotion.viewpromo']}}
{{$productOrderCtrl.translations['antibody.pdp.commerceCard.promotion.promocode']}}: {{promo.promoCode}} {{promo.promoTitle}} {{promo.promoDescription}}. {{$productOrderCtrl.translations['antibody.pdp.commerceCard.promotion.learnmore']}}
图: 1 / 4
RXRG Antibody (PA5-110337) in IHC (P)




Please note: We are reviewing Western blot images included in the antibody testing data in our catalog, including those provided by third parties. Unless expressly labeled or annotated as “raw-unedited”, Western blot images included in the antibody testing data in our catalog may have been edited, optimized or otherwise adjusted for presentation.
产品信息
PA5-110337
种属反应
宿主/亚型
分类
类型
抗原
偶联物
形式
浓度
规格
纯化类型
保存液
内含物
保存条件
运输条件
RRID
产品详细信息
Immunogen sequence: MYGNYSHFMK FPAGYGGSPG HTGSTSMSPS AALSTGKPMD SHPSYTDTPV SAPRTLSAVG TPLNALGSPY RVITSAMGPP SGALAAPPGI NLVAPPSSQL NVVNSVSSSE DIKPLPGLPG IGNMNYPSTS PGSLVKH
靶标信息
Retinoic Acid (RA; active metabolite of vitamin A) plays a prominent role in regulating the transition of proliferating precursor cells (such as carcinoma cells and neuronal precursors) to postmitotic differentiated cells (Joshi et al., 2005). The Retinoid X Receptors (RXRs) family (RXR alpha, beta, and gamma), preferentially bind 9-cis -RA and regulate gene transcription by forming heterodimers with a second family of RA receptors. RAs have been suggested to potentially play a therapeutic role in cervical cancer (Abu et al., 2005). RAs are known to play key roles in neuronal development and an increasing body of evidence indicates that retinoid signaling may regulate synaptic plasticity and associated learning and memory behaviors (Lane and Bailey, 2005).
⚠WARNING: This product can expose you to chemicals including mercury, which is known to the State of California to cause birth defects or other reproductive harm. For more information go to www.P65Warnings.ca.gov.
仅用于科研。不用于诊断过程。未经明确授权不得转售。
篇参考文献 (0)
生物信息学
蛋白别名: Nuclear receptor subfamily 2 group B member 3; Retinoic acid receptor RXR-gamma; retinoic X receptor gamma-1; retinoid X receptor; Retinoid X receptor gamma; RXR gamma; RXR gamma-1
基因别名: NR2B3; RXRG
UniProt ID: (Rat) Q5BJR8, (Mouse) P28705
Entrez Gene ID: (Rat) 83574, (Mouse) 20183